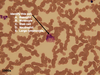

Exam III - Practice Exam Flashcards
(50 cards)

C. Thyroglobulin

C. Thyrotropin releasing hormone
Identify the region in the box

D. Medulla
Choose the letter box indicating the lamina muscularis mucosae.

D
This is a:

A. marrow aspirate
The indicated structures are found in the _______

C. neurohypophysis
Identify this cell

A. Monocyte
Identify this cell
A. Basophil
The indicated cells become mature ______.

C. neutrophils
Choose the species from which this tissue was taken

B. Llama
The arrows indicate _____.

C. thrombocytes.
What does the indicated cell produce?

E. Antibodies
The organ depicted is _______.

E. the thymus
This is the tunica _________

D. serosa
The indicated cells are _____.

D. immature erythrocytes
These lymphatic structures (arrows) are part of _____.

C. GALT (Peyer’s Patches)
Identify the organ filling the field.

B. Spleen
What specific term is given to the mass of cells enclosed by the line? (This is a zoomed in image of the speen)

D. Periarteriolar lymphatic sheath
Identify the immature cells in the box.

B. T lymphocytes
Identify the cells forming the distinctive structure in the circle.

E. Epithelioreticular cells
Name the hormone directly stimulating activity of the cells in the structure indicated by the bar.

A. Growth Hormone
Identify the organ region in this box.

B. Adenohypophysis
Identify the indicated part of the organ.

A. Pars Intermedia
Name a hormone produced by the acidophilic cells.

D. Growth hormone





















